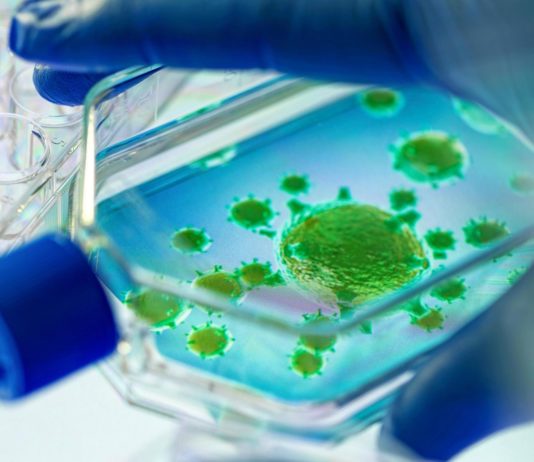
Covid-19: 11 Personen positiv auf die englische Variante in einem Toulouser Altersheim getestet

Die Bescheinigung für Ausgänge, die nicht der 18-Uhr-Sperrstunde unterliegen, hat sich in den letzten Tagen geändert. Ein spezieller Hinweis auf die Impfkampagne wurde eingefügt.
Dies ist ein weiterer Beweis für die Bereitschaft der Behörden, das Tempo...
Covid-19: In welchem Gemütszustand befinden sich die Franzosen vor einem möglichen dritten Lockdown?
Am Sonntag, dem 24. Januar, konnten die Franzosen noch etwas Freiheit genießen, bevor die Ausgangssperre um 18 Uhr einsetzte. Aber für wie lange noch? Franceinfo führte eine kleine Umfrage auf der Strasse durch:
Der dritte Lockdown...
Lockdown oder nicht, das Thema hat an diesem Wochenende die Debatte in den sozialen Netzwerken entfacht.
Als Zeichen eines spürbaren Gefühls der Genervtheit, da die Gefahr eines dritten Lockdowns mehr denn je über dem Land...
Emmanuel Macron hatte am Sonntagabend einen ersten Kontakt mit dem amerikanischen Präsidenten Joe Biden. Der Élysée-Palast berichtete von einer "großen Konvergenz der Ansichten", vor allem in Bezug auf Covid-19 oder das Klima.
Emmanuel Macron und Joe...
Mehr als 18.000 neue Covid-19-Kontaminationen wurden an diesem Sonntag in Frankreich registriert. 172 Menschen starben an dem Virus. Der Präsident des wissenschaftlichen Rates Jean-François Delfraissy ist der Meinung, dass "es wahrscheinlich notwendig sein wird, auf...
In Toulouse (Haute-Garonne) wurden 11 Personen in einem Altersheim positiv auf die englische Variante getestet.
Dies ist das erste Mal, dass die britische Variante in einem Altersheim in Toulouse (Haute-Garonne) entdeckt wird. Elf Personen wurden in...
Dies sei der erste Austausch zwischen den beiden Staatsoberhäuptern seit der Amtseinführung des neuen amerikanischen Präsidenten, hieß es im Elysée.
Eine neue, bessere Beziehung in Sicht. Emmanuel Macron wird am Sonntagabend, 24. Januar, telefonisch mit dem...
Was wird die Regierung in den kommenden Wochen entscheiden? Während sich das Schreckgespenst eines dritten Lockdowns zu bestätigen scheint, zögert die Regierung eine Entscheidung hinaus.
Das Virus zirkuliert intensiv in Frankreich, wo es im Durchschnitt täglich...
Regierungssprecher Gabriel Attal war an diesem Sonntag, 24. Januar, zu Gast bei Dimanche en politique. Die Gelegenheit zu einer Bestandsaufnahme der Gesundheitssituation und einem möglichen dritten Lockdown.
Lockdown. Dieses Wort steht auf den Titelseiten der Presse...
Die Regierung stünde kurz vor der Entscheidung über einen dritten Lockdown, berichtet das Journal du Dimanche. Emmanuel Macron könnte es nächste Woche verkünden, sagen unsere Kollegen. Die Schulen würden aber geöffnet bleiben.
Ein dritter Lockdown in...